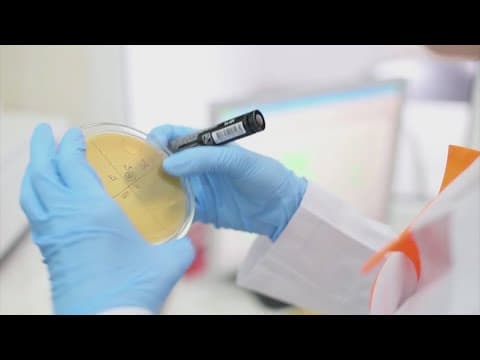
Houston news: 7 human cases of West Nile virus reported in Harris County

Loading...
Related Footage

Update on standoff in NW Harris County
Update on standoff in NW Harris County
00:06:06 - Youtube video: pngtEvuTXZo

Judge sides with Harris County on program to give families $500 a month
Judge sides with Harris County on program to give families $500 a month
00:02:48 - Youtube video: G7SlJrbEBBk

Law enforcement gives update after human remains found in northeast Harris County home
Law enforcement gives update after human remains found in northeast Harris County home
00:02:44 - Youtube video: WmiJD7s90wk

Harris County Judge Lina Hidalgo delivers State of the County address
Harris County Judge Lina Hidalgo delivers State of the County address
00:47:15 - Youtube video: hrE4Vxl6II8

Harris County homeowners face deadline to protest property appraisals
Harris County homeowners face deadline to protest property appraisals
00:01:35 - Youtube video: Nl53C4F1c_8

Harris County sues Trump administration, cites threat to hurricane season preparedness
Harris County sues Trump administration, cites threat to hurricane season preparedness
00:00:42 - Youtube video: wgacgzV9-38

Harris County to vote on putting burn ban in place
Harris County to vote on putting burn ban in place
00:01:47 - Youtube video: 0UpAQP55jt0
Leaders alert Harris County childcare facilities of property tax exemption application deadline
Leaders alert Harris County childcare facilities of property tax exemption application deadline
00:01:04 - Youtube video: IpULfb30mcs